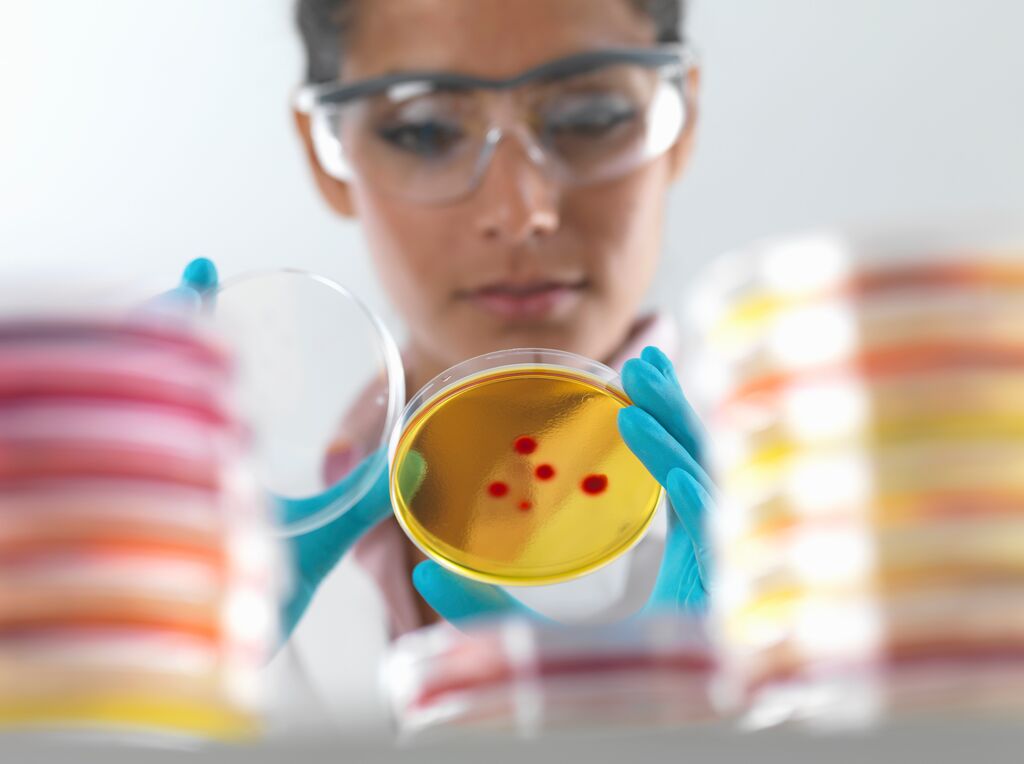
Bioburden Testing

Sterilization is a process that inactivates any microbiological contaminants and converting non-sterile products into sterile ones. Healthcare sterile products are required to be at their highest quality prior to use. One of the vital aspects for these sterile products is that they should be free of viable microorganism.
Sterilization is a process that inactivates any microbiological contaminants and converting non-sterile products into sterile ones. Healthcare sterile products are required to be at their highest quality prior to use. One of the vital aspects for these sterile products is that they should be free of viable microorganism.
How can you ensure your sterile products have undergone effective sterilization process?
Bioburden test determines total number of viable microorganisms present on or in a product and/or sterile barrier system.
Bioburden testing are required by manufacturers to serve as early detection sign on possibility of production issues, contamination, or improper sterilization. Any high detection of bioburden may lead to product recalls and even may pose a risk to patients.
Some of the probable sources of bioburden are as below (non-exhaustive).
- Raw materials
- Manufacturing components
- Processes during assembly
- Production floor environment
- Assembly or manufacturing aids
- Cleaning processes
- Production personnel
- Finished goods packaging
Why choose bioburden testing from SGS?
We provide:
- Reliable bioburden testing in accordance to ISO 11737-1 standard
- Testing of how many microorganism population living on the surface of your medical device that has not completely sterilized
- Bioburden validation test for all new samples – we shall assess the suitability of test method to demonstrate lack of inhibition growth, bioburden recovery efficiency, and suitability of the microbial characterization technique.
- Bioburden routine test
CNY festive promotion
In conjunction with the CNY festive season, we are delighted to offer you special promotion of FREE ONE bioburden routine test for every bioburden validation test request.
Claim this offer by using promo code CNYBBD22
Valid until February 28, 2022.
Click here to get your offer!
For more details, please contact:
Connectivity & Products
Mr. Khairul Hazwan
Email: khairul.hazwan@sgs.com
Lot No. 4 Persiaran Jubli Perak, Seksyen 22,
40300 ,
Shah Alam, Selangor, Malaysia



